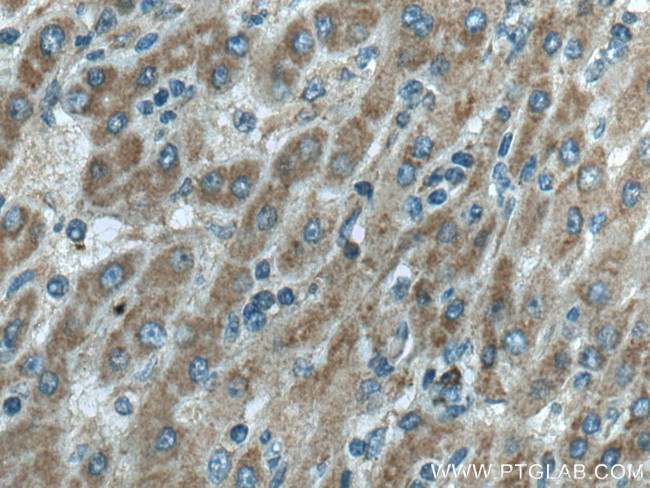
RFTN2 Antibody in Immunohistochemistry (Paraffin) (IHC (P))

Search
Proteintech
RFTN2 Polyclonal Antibody
{{$productOrderCtrl.translations['antibody.pdp.commerceCard.promotion.promotions']}}
{{$productOrderCtrl.translations['antibody.pdp.commerceCard.promotion.viewpromo']}}
{{$productOrderCtrl.translations['antibody.pdp.commerceCard.promotion.promocode']}}: {{promo.promoCode}} {{promo.promoTitle}} {{promo.promoDescription}}. {{$productOrderCtrl.translations['antibody.pdp.commerceCard.promotion.learnmore']}}
产品信息
17854-1-AP
种属反应
宿主/亚型
分类
类型
抗原
偶联物
形式
浓度
规格
纯化类型
保存液
内含物
保存条件
运输条件
产品详细信息
Immunogen sequence: CGLRKLEDP DDSSPGKIFS TLKRPQVETK TEFAYEYVLL DFTLQASSNP EVIKINSILD IVTKVENYYL KGYIVGAIHP VIQPVGQRKH LPASYLYRVV LLRLKLSPKN SAAPSGQRRP RLVIEECPLT SEAQTNDAAK ELIEKINVAA KRGMKFVGFI SQHYSPSKFC NGTNHDGDIE SMLHVRHGSD ENCRSWNEGT LSGQSSESGI EEELHHESGQ YQMEQNGSPT SSKSRKGEAS DNKLYTVFNA FDDDSTSWAY QEGILSMKVT RKGSVISTLD ADWLELTTFY YKQGLSLIDS FVFWETSKGE HLPKSLEGFF IYEEEGSGVP GSSRKGNDAI VVEQWTVIEG CEIKTDYGPL LHTLAEFGWL LTSVLPTPVL RHDSEGNLAT KQIVFLQRPV MWNSAAQTPD KKASRHIKGE DKNKATSRSI GLDTTSSQPA ESRHLPEECR LSPSRECWTK EGRLAQHNSF SGFSSSDNVL RELDDGQFDQ EDGVTQVTCM (3-501 aa encoded by BC111069)
靶标信息
Upon bacterial lipopolysaccharide stimulation, mediates clathrin-dependent internalization of TLR4 in dendritic cells, resulting in activation of TICAM1-mediated signaling and subsequent IFNB1 production. May regulate B-cell antigen receptor-mediated signaling.
仅用于科研。不用于诊断过程。未经明确授权不得转售。
篇参考文献 (0)
生物信息学
蛋白别名: Raft-linking protein 2; Raftlin-2; unnamed protein product
基因别名: 2700010E02Rik; 3222401M22Rik; C2orf11; Raftlin-2; RFTN2
UniProt ID: (Human) Q52LD8, (Mouse) Q8CHX7
Entrez Gene ID: (Human) 130132, (Mouse) 74013